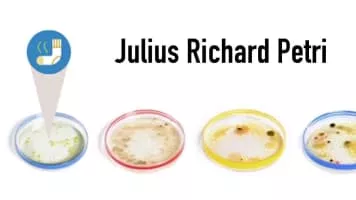

Julius Richard Petri
| Use attributes for filter ! | |
| Gender | Male |
|---|---|
| Death | 104 years ago |
| Date of birth | May 31,1852 |
| Zodiac sign | Gemini |
| Born | Barmen |
| Germany | |
| Date of died | December 20,1921 |
| Died | Zeitz |
| Germany | |
| Residence | Berlin |
| Germany | |
| Nationality | German |
| Prussian | |
| Fields | Microbiology |
| Military medicine | |
| Surgeon | |
| Education | Kaiser-Wilhelm-Akademie Medizin |
| Charité – Universitätsmedizin Berlin | |
| Date of Reg. | |
| Date of Upd. | |
| ID | 1090001 |
Julius Richard Petri Life story
Julius Richard Petri was a German microbiologist who is generally credited with inventing the device known as the Petri dish, which is named after him, while working as assistant to bacteriologist Robert Koch.